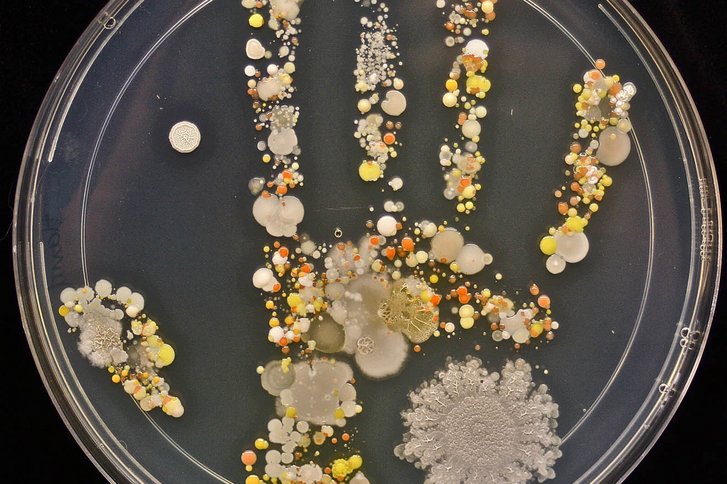

Was ist Hygiene?
Hygiene ist die Lehre von der Verhütung von Krankheiten und der Erhaltung, Förderung und Festigung der Gesundheit - kurz gesagt, die Gesundheitslehre. Wenn man heute von Hygiene spricht, fällt häufig der Begriff Infektionsprävention (= Verhütung von Krankheiten).
Infektionsprävention
Für unsere schwer betroffenen Patienten können multiresistente Erreger eine Gefahr darstellen. Wir möchten ihnen mit den folgenden Maßnahmen einen bestmöglichen Schutz vor einer Infektion bieten.
- Hygienemanagement nach den Empfehlungen und Vorgaben des Robert Koch-Instituts
- Zugriff auf den Hygiene- und Erregerleitfaden für alle Mitarbeiter der Klinik
- risikoadaptiertes Screening (Abstrichuntersuchungen auf relevante Erreger)
- tägliche Erfassung der wichtigsten Erreger nach § 23 Infektionsschutzgesetz mit der Möglichkeit zur Darstellung der Infektionsstatistik, die präventiv schnelles Handeln ermöglicht
- regelmäßige Schulungen für alle Mitarbeiter nach den gesetzlichen Vorgaben und anlassbezogen
- Teilnahme am Krankenhaus-Infektions-Surveillance-System (KISS = Erfassung von nosokomialen Infektionen) beim Nationalen Referenzzentrum (NRZ)
- Umsetzung der gesetzlichen Vorgaben
- Zusammenarbeit mit dem Gesundheitsamt
- ein erfahrenes Hygieneteam
Unser Hygieneteam
- ein externen Krankenhaushygieniker
- ein hygienebeauftragter Arzt
- drei Hygienefachkräfte
- hygienebeauftragte Pflegekräfte auf den Stationen
Ihre Fragen beantwortet unser Team gerne. Sie erreichen uns telefonisch über die zentrale Rufnummer der Klinik: +49 2324 966-0 oder per E-Mail an info.hattingen@vitrea-gesundheit.de.